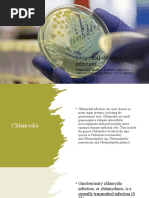

Chlamydia
Family- Chlamydiaceae
Genus- Chlamydia
C. trachomatis- Trachoma, conjunctivis, pneumonia, lymphogranuloma.
C. psittaci- Causes pneumonia
C. pneumoniae- Bronchitis, sinusitis, pneumonia
Chylamidia pecorum
�• C. trachomatis is a small gram neagtive bacterium.
• It is the most common cause of bacterial sexually
transmitted infection.
• Majority of patients are asymptomatic hence provide
ongoing resorvor for infection.
• Infants born to mothers with infected birth canal,
conjuctivitis and pneumonia can occur.
• Other forms of trachoma infection include lymphagranuloma
venerum (LGV) and endemic trachoma.
• Incubation period of symptomatic disease ranges from 5-14
days following infection.
� Clinical sydromes
Clinical sydrome in female
Although majority of females with C. trachomatis infection are asymptomatic, the pathogen
is an important cause of several common clinical syndromes as heighlighted below:
Genitourinary Tract Infection- Cervix is commonly infected. If untreated, it can ascend to
cause PID and its sequalae of infertility and chronic pelvic pain.
Urethra can also be infected.
Cervicitis- Mojority of females infected at the cervix have neither signs nor symptoms.
When symptoms occur, they are highly non-specific and can easily be confused with other
causes of vaginitis.
Dysuria-pyuria sydrome due to urethritis- mimics UTI symptoms. Urinalysis reveals pyuria
but no bacteruria.
Pelvic inflammatory Disease- Sequalae of untreated cervicitis.
Perihepatitis sydrome (Fitz-Hugh-Curtis sydrome)-RUQ and pleuritic pain in a setting of
acute PID. LFT will be normal.
Complication of pregnancy- Future ectopic pregnancy following PID, PROM, Preterm
deliveries and LBW
� Clinical sydromes in Male
• Urogenital infection- Urethritis- C, trachomatis is the most
common cause of urethritis in males. Mostly asymptomatic.
• Symptoms typically is mucoid or watery urethral discharge
and dysuria.
• The discharge is clear and is appreaciated upon milking the
urethra.
• Sometimes it is so scanty that men notice stained
undergarments in the morning.
• Incubation period is 5-10 days after exposure.
• This is in contrast to the shorter (2-7 days) incubation period
for gonococcal urethritis.
�• Epididymitis-C. trachomatis is one of the most
frequent pathogens in epididymitis along with N.
gonorrhaea.
• Males with acute epididymitis typically present
with unilateral testicular pain, tenderness,
hydrocele and palpable swelling of the epididymis.
• Prostatis- Chronic prostatitis. S/S-dysuria, urinary
dysfunction, pain with ejaculation and pelvic pain.
�Clinical sydromes common in both M/F
• Conjuctivitis
• Pharygitis
• Proctitis
• Lypha Granuloma Venerum (LGV)
• Reactive arthritis
� LGV
1st stage
• Small painless vesicular lesions at the infection site.
• Fever, Headache and mylagia
2 stage
• Inflammation of draining lymphnodes
• Fever, Headache and mylagia
• Buboes rupture and drain
• Proctitis
• Ulcers/ Elephantiasis
�� Diagnosis
• Preferred specimen- Genital swab, First void
urine is the preferred specimen.
• Microscopy
• Culture
• NAAT (prefered)
• Rapid test-
• Serology- Infrequently done
� Treatment
Goals:
• To prevent complications
• Decrease the risk of transmission to others.
• Resolve symptoms
• Prevent reinfection
� Treatment Ct..
• Doxycycline 100mg bdx1/52 is the DOC. Or
• Azithromycin 1g stat
• Levofloxacin 500mg odx1/52 or ofloxacin 300mg
bdx1/52 (should be used if no other option)
Evaluate for and treat gonoccal coinfection.
All patients with chlamydia should be tested for
gonorrhea.
Screen for HIV and other STIs.
For pregnant women- avoid doxycyline
�DDx
???
�The End,,
*******